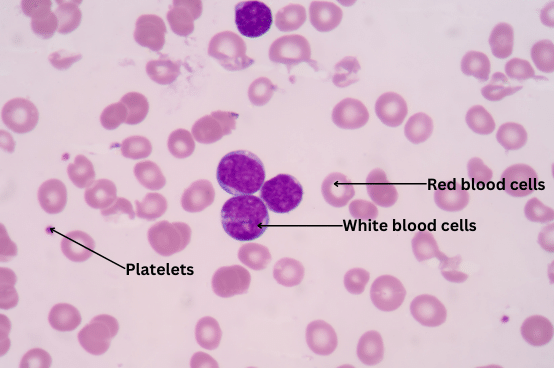
Different types of cells in blood.

4. Complete Activity 6.4 (Page 66). Take a drop of blood on a slide and observe different cells present in it under a microscope.
Answer:
Aim: To observe different blood cells under the microscope and conclude based on that.
Materials Required: Drop of blood, slide, microscope.
Procedure:
(i) A drop of blood is taken on a slide.
(ii) The different cells present in it are observed under a microscope.
Observations:
Some different cells in blood are labelled below:
Conclusions: Blood contains red blood corpuscles (RBC), white blood corpuscles (WBC), and platelets. There are several types of white blood cells, including neutrophils, lymphocytes, monocytes, eosinophils, and basophils.
“Take a drop of blood on a slide and observe different cells present in it under a microscope.” – Solved.
Related Links:
Solution to Activity 6.1
Solution to Activity 6.2
Solution to Activity 6.3
Solution to Activity 6.4
Solution to Activity 6.5
Solutions to Chapter 6 Tissues


